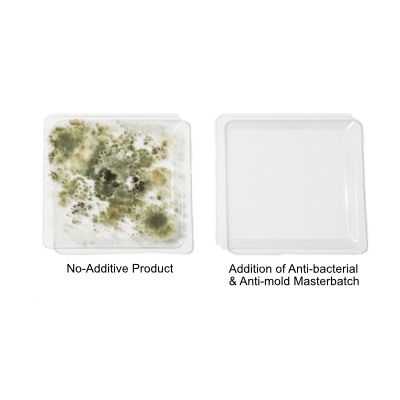

This product is meticulously formulated with advanced clarifying agents to significantly enhance the transparency of polypropylene (PP). It achieves glass-like clarity at specific wall thicknesses, thereby elevating the aesthetic quality of the final product. Additionally, this product enables lower processing temperatures and shorter molding cycles, contributing to improved production efficiency.This masterbatch is widely applied in industries such as food packaging, baby bottles, cosmetic packaging, and medical packaging. Depending on the manufacturing process, we offer transparent masterbatches suitable for both injection molding and thermoforming applications.

This product is designed for use in packaging containers made of materials such as PE, PP, and PET, offering UV protection up to 395nm. Prolonged exposure to ultraviolet (UV) radiation can lead to nutrient loss, discoloration, and spoilage in products such as food, beverages, and cosmetics, adversely affecting their storage and marketability. The product effectively safeguards nutritional content and color, significantly extending the shelf life of products. Additionally, the UV-blocking masterbatch can be customized to various colors based on customer requirements.

This product, through a specially designed formulation, significantly enhances the hydrophobic properties of plastic surfaces, effectively reducing liquid residue on the product surface without impacting its assembly performance. Tailored to customer requirements, we offer a variety of solutions. This masterbatch is widely used in laboratory consumables such as pipette tips and deep-well plates.

This product is primarily used in the field of sterilization protection, enhancing the stability of polymers under gamma-ray irradiation. It minimizes polymer degradation and the decline of physical properties while preventing product yellowing. Customers can freely adjust the masterbatch addition ratio based on varying irradiation intensities. The product is widely applied in syringes, medical consumables, and pharmaceutical packaging products.

This product is primarily used for PP and PE bottle caps in the food and beverage industry, significantly improving sealing and opening torque, reducing high distortion caps, and enhancing production efficiency. It also offers excellent sensory properties and stability, addressing issues such as precipitation and odor caused by traditional additives.

This product is suitable for resin systems such as PE, PP, PET, PS, TPU, and TPE, particularly in the blown film and cast film industries. It provides internal and external lubrication properties, reduces the coefficient of friction, minimizes scratches, and facilitates winding. The product features high transparency, low haze, and excellent performance in heat sealing, printing, and lamination without any adverse effects.

This product is designed to reduce and eliminate static charge accumulation on the surface of plastic products, providing dust prevention and protection against electrostatic discharge to safeguard electronic components. Depending on the application, we offer both migratory and permanent antistatic masterbatches, with surface resistivity reaching 106-1011ohm/sq. For specific industries, such as the medical device sector, we also provide amine-free antistatic solutions.
This product effectively eliminates and inhibits the growth of bacteria and mold on plastic surfaces, with a high anti-bacterial efficacy reaching up to 99% and an anti-mold effect achieving Level 1 or Level 0. It offers long-lasting antibacterial performance, essentially equivalent to the product's service life, along with excellent heat resistance and no discoloration. The product is widely applied in industries such as household appliances, textile fibers, kitchenware, automotive, packaging, pipes, and building materials.

This product is primarily designed to protect polymers from degradation caused by light and heat, thereby extending the service life of the products. Tailored stabilizers are employed to address the aging mechanisms of different materials, ensuring optimal anti-aging performance. It is widely used in automotive interior components, outdoor seating, sports facilities, sun panels, textiles, and other outdoor plastic products.

This product series offers a wide range of anti-fog solutions tailored to different anti-fog performance requirements. The anti-fog agent migrates to the polymer surface, forming a continuous and uniform water film on the product surface to prevent fogging, thereby preserving the aesthetic appeal and light transmission of packaged products. It is widely used in food packaging and agricultural greenhouse film applications.

This product absorbs ultraviolet light and short-wave blue light below 460nm, making it suitable for manufacturing blue-light-blocking films, sheets, and lenses. It effectively shields high-energy short-wave blue light emitted from electronic screens such as mobile phones and computers, protecting the retina and preventing macular degeneration. The product can be used to produce films or sheets made from PET, PE, PP, PC, PMMA, and other materials.
